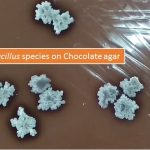
Bacillus species on Chocolate agar

Collection Group: Clinical Bacteriology
Nocardia in Acid Fast Stain: Introduction, Principle, Procedure and Result Interpretation
 Nocardia in Acid-fast stain Nocardia species in acid-fast stain showing...
Nocardia in Acid-fast stain Nocardia species in acid-fast stain showing...
Bacillus species: Introduction, Classification and About Bacillus anthracis and cereus
Introduction Bacillus species Bacillus species on Chocolate agar as shown...
Introduction Bacillus species Bacillus species on Chocolate agar as shown...
Gram Positive Bacteria: Gram Stain Introduction,Principle, Procedure and Result-Interpretation
 Introduction Gram-positive bacteria in Gram stain as shown above image. ...
Introduction Gram-positive bacteria in Gram stain as shown above image. ...
